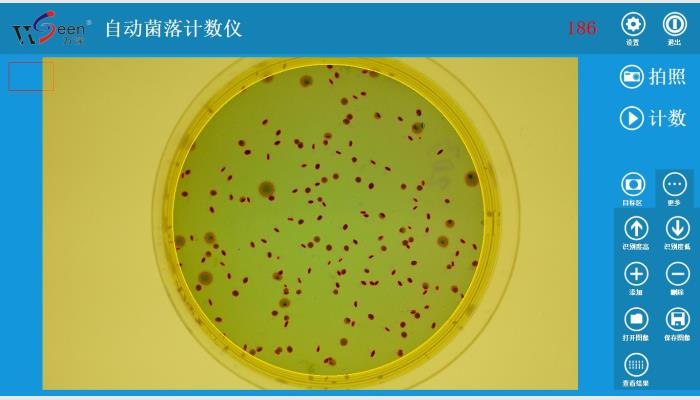

一、用途
用于微生物、菌落總數(shù)的自動計數(shù)分析,快速、有效替代半自動計數(shù)菌落的落后工作方式。
二、主要技術(shù)指標(biāo)
1、用大景深的1200萬像素拍攝儀拍照菌落平皿,懸浮暗視野、背光可切換成像分析,超薄LED背光成像裝置使自動計數(shù)識別更穩(wěn)定,可長時間工作。
2、適應(yīng)培養(yǎng)皿直徑:50~120mm平皿(傾注、膜濾、3M紙片)。
3、可自動計數(shù)和輸出菌落總數(shù),自動識別計數(shù)≥0.1mm的菌落,自動計數(shù)精度≥96.5%,由添加、刪除的個別指點修正,可使計數(shù)值達(dá)100%準(zhǔn)確。分析速度:50~500個菌落/s(計數(shù)分析耗時1~4秒)。
4、可自動分割鏈狀或團(tuán)狀粘連的各類菌落。
5、可自動過濾剔除雜質(zhì)和點擊修正等操作,有效支持復(fù)雜微生物統(tǒng)計。
6、可查看結(jié)果表、并導(dǎo)出至EXCEL,可存上萬張圖片及其對應(yīng)的數(shù)據(jù),并無線上網(wǎng)來遠(yuǎn)程發(fā)送圖片、結(jié)果數(shù)據(jù)。
三、標(biāo)準(zhǔn)配置
1、HiCC-B全自動菌落計數(shù)儀系統(tǒng)軟件U盤及軟件鎖1套
2、大景深的1200萬像素拍攝儀1臺
3、A5幅面白底背光板和平皿定位擋1套
4、暗視野背景黑片1片
備注:
可特殊定制適應(yīng)更大平皿的。本產(chǎn)品需使用電腦,推薦選配:品牌電腦(酷睿i5九代以上CPU / 8G內(nèi)存/ 21.5”彩顯/無線網(wǎng)卡,4個以上USB2.0口,運行環(huán)境Windows 10完整專業(yè)版)。
搜索
產(chǎn)品類別
相關(guān)產(chǎn)品
- HiCC-F全自動抑菌圈測量儀、抗生素效價測定儀 >
- HICC-A2全自動菌落計數(shù)分析儀,菌落計數(shù)儀,自動菌落計數(shù)儀,菌落計數(shù)器 >
- HiCC-B1 automatic colony counter,自動菌落計數(shù)儀,菌落計數(shù)器 >
- HiCC-E型β-內(nèi)酰胺酶檢驗分析儀系統(tǒng),抑菌圈測量儀,抑菌圈測定儀,抗生素效價測定儀 >
- HiCC-B1型全自動菌落計數(shù)儀,菌落計數(shù)儀,自動菌落計數(shù)儀,菌落計數(shù)器 >
- HiCC-B型全自動菌落計數(shù)儀,菌落計數(shù)儀,自動菌落計數(shù)儀,菌落計數(shù)器 >
- HiCC-S1全自動菌落計數(shù)及抑菌圈測量儀系統(tǒng),菌落計數(shù)儀,抑菌圈測定儀 >
- WSeen’s HiCC-B automatic colony counter >
- HiCC-D全自動菌落計數(shù)分析儀系統(tǒng),菌落計數(shù)儀,自動菌落計數(shù)儀,菌落計數(shù)器 >
- HiCC-T全自動抑菌圈測量儀,抑菌圈測定儀,抗生素效價測定儀,藥敏分析儀 >
- HiCC-P型全自動抑菌圈測量儀系統(tǒng),抑菌圈測定儀,抗生素效價測定儀 >
- HiCC-Z組合型全自動菌落計數(shù)、抑菌圈測量、β-內(nèi)酰胺酶檢測、顯微分析儀系統(tǒng) >
- HiCC-Z全自動菌落計數(shù)、抑菌圈測量、β-內(nèi)酰胺酶檢驗儀 >
- HiCC-V全自動菌落計數(shù)儀、抑菌圈測量儀、細(xì)胞計數(shù)分析系統(tǒng) >
- 萬深HiCC-D型全自動菌落計數(shù)分析儀 >

